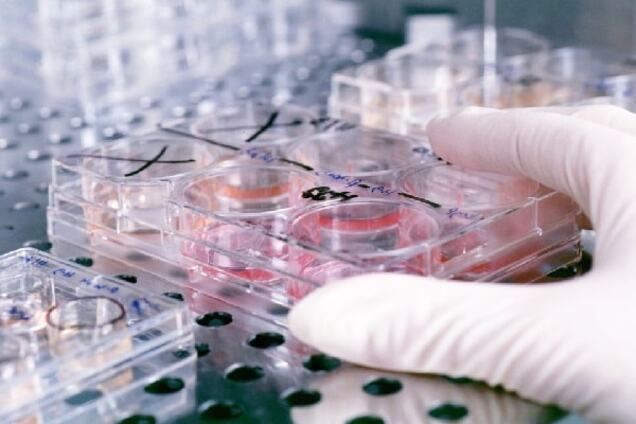
Гомункулюс: новости из пробирки

Блог | Гомункулюс: новости из пробирки
В мире еще не научились клонировать человека. Но, по крайней мере, один украинский олигарх, очевидно вдохновленный появлением овечки Долли, решил уже сегодня сделать прорыв в науке – за свой счет клонировать Президента Украины.
Генетическая информация, использованная для проведения эксперимента, была взята прямиком из взрослых клеток заказчика.
За право осуществления эксперимента боролись несколько научных центров, как в Украине, так и за рубежом. В конце концов, предпочтение было отдано заокеанским ученым, гарантировавшим чистоту эксперимента. Предложения отечественных специалистов были отвергнуты, поскольку, как выяснилось в процессе конкурса, все они знали старый и не очень приличный анекдот "ну Бельмондо, так Бельмондо…".
Работа, начатая больше года назад, просто кипит, причем как в киевском офисе, так и заокеанских научных центрах, подрядившихся вырастить Гомункулюса. Продукт нужен вовремя и оговоренного качества. Времени на распевку практически нет - презентацию результатов эксперимента украинскому народу срывать нельзя.
Главное требование заказчика, имеющего далеко идущие планы, касается не столько экстерьера, сколько нейролингвистического программирования искусственно выведенного существа. Сложность задачи заключается в том, что Гомункулюс должен вобрать в себя ровно столько и таких черт заказчика, чтобы навсегда оставаться с ним в неразрывной связи. И при этом не стать абсолютным двойником, который ненароком cмог бы претендовать на разнообразные права собственности заказчика.










